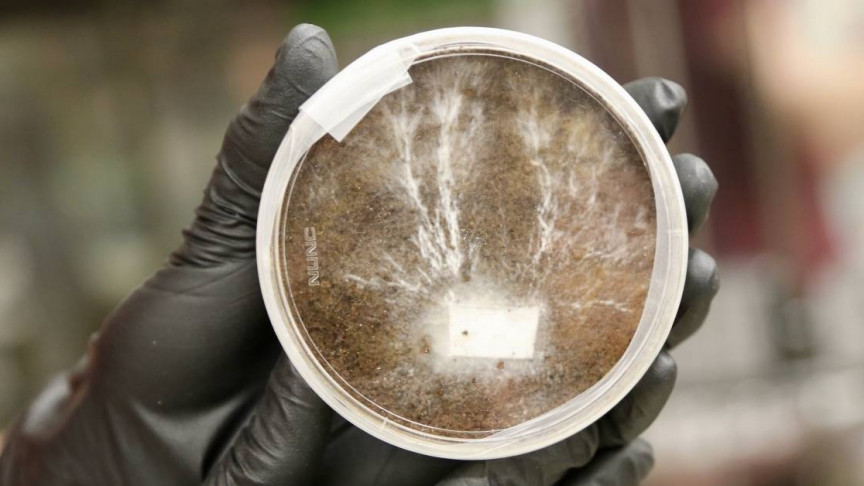

What do you imagine life on the Moon and Mars might be like? Do you imagine futuristic buildings made of metal? Well, NASA imagines some a lot more sustainable options.
RELATED: UNDERGROUND FUNGI NETWORK MAPPED FOR THE FIRST TIME
The agency is working on buildings made of fungi. Yes, you read that correctly… Fungi!
Called the myco-architecture project and run by NASA’s Ames Research Center in California’s Silicon Valley, this new initiative is seeking to “grow” habitats on the Moon, Mars, and even potentially Earth.
Like a turtle
“Right now, traditional habitat designs for Mars are like a turtle — carrying our homes with us on our backs – a reliable plan, but with huge energy costs,” said in a statement Lynn Rothschild, the principal investigator on the project. “Instead, we can harness mycelia to grow these habitats ourselves when we get there.”
What they envision is straight out of a science fiction film. Space explorers would carry with them compact habitat built out of lightweight material with dormant fungi.
Once in their final destination, the explorers would simply add water and the fungi would grow across that framework creating a living habitat. Of course, we are a long way off from this happening.
Still, early-stage research is seeking to prove that such structures could be viable options. How would these structures look like?
Three-layered domes
NASA describes them as three-layered domes:
“The outer-most layer is made up of frozen water ice, perhaps tapped from the resources on the Moon or Mars. That water serves as a protection from radiation and trickles down to the second layer – the cyanobacteria. This layer can take that water and photosynthesize using the outside light that shines through the icy layer to produce oxygen for astronauts and nutrients for the final layer of mycelia.
That last layer of mycelia is what organically grows into a sturdy home, first activated to grow in a contained environment and then baked to kill the life-forms – providing structural integrity and ensuring no life contaminates Mars and any microbial life that’s already there.”
NASA also believes that their project has applications right here on Earth. It could provide a more eco-friendly and sustainable method of living.
What do you think? Would you be interested in living in a fungi home?
[embedded content]












